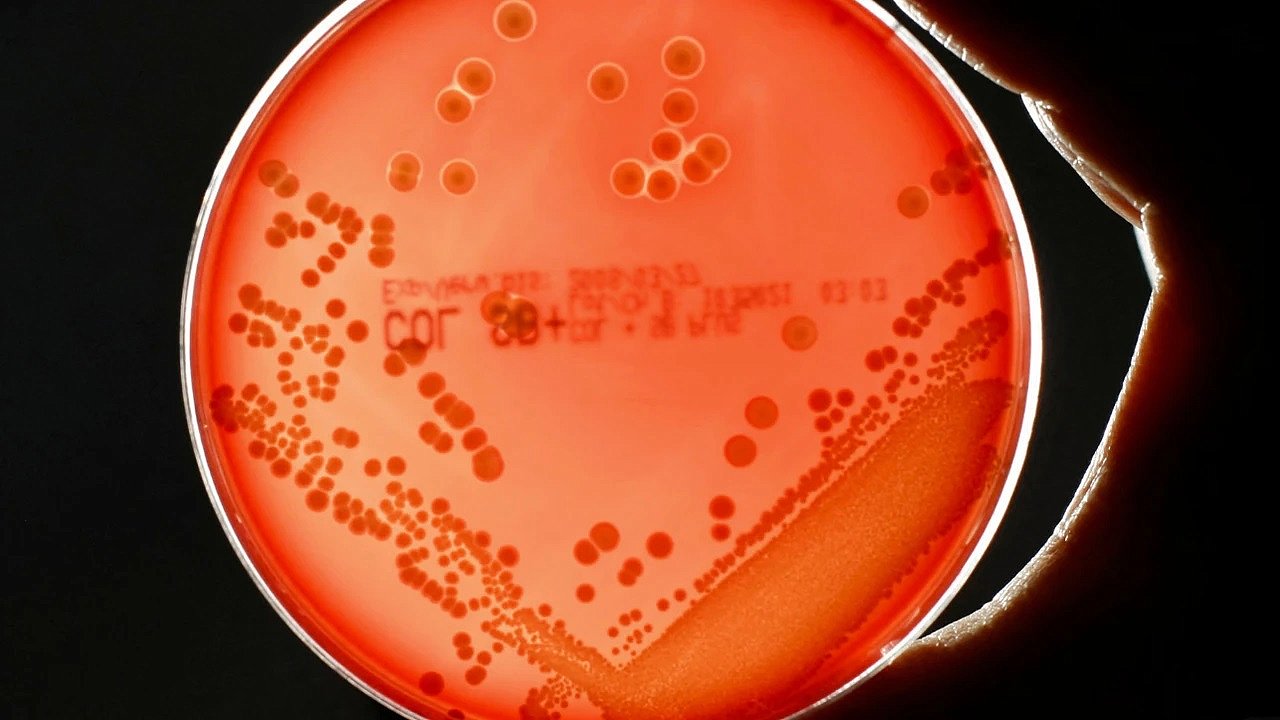

Bu tahmin, antibiyotik direncindeki (AMR) artışın etkilerini modelleyen bir çalışmadan elde edildi.
İngiltere hükümeti tarafından finanse edilen bir araştırma, kapsamlı ve kararlı önlemler alınmadığı takdirde, artmış antimikrobiyal direnç oranlarının önümüzdeki çeyrek yüzyıl boyunca küresel GSYİH’de yıllık 1,7 trilyon dolarlık kayba yol açabileceğini gösterdi.
Center for Global Development (Küresel Kalkınma Merkezi) adlı düşünce kuruluşu tarafından yapılan araştırmaya göre, ABD, Birleşik Krallık ve AB ekonomileri en sert şekilde etkilenecek. Bu da son dönemdeki büyük ölçekli dış yardım kesintilerinin “kendi ayağına kurşun sıkmak” anlamına geldiğine dair eleştirileri beraberinde getirdi.
Perşembe günü İngiltere hükümeti, düşük ve orta gelirli ülkelerde antimikrobiyal dirençle mücadele eden "Fleming Fonu"nun fonlarının kesileceğini duyurdu. Bu karar, daha geniş kapsamlı yardım kesintilerinin bir parçası olarak açıklandı. Trump yönetimi de dış yardım bütçesinden 9 milyar dolarlık kesintiyi onayladı. Diğer bazı Avrupa ülkeleri de yurt dışı yardım harcamalarını azaltmış durumda.
Araştırmanın baş yazarı ve Center for Global Development’ta araştırma ve politika uzmanı olan Anthony McDonnell şunları söyledi:
“Antimikrobiyal direncin ekonomik etkilerini araştırırken, direnç oranlarının tarihsel eğilimleri izleyeceğini varsaymıştık.
Ancak, ABD’nin resmi kalkınma yardımlarını yaklaşık %80 oranında kesmesi, İngiltere’nin GSYİH içindeki yardım oranını %0,5’ten %0,3’e indirmesi ve Fransa, Almanya gibi ülkelerin de önemli azaltmalara gitmesi, direnç oranlarını en kötümser senaryomuza yaklaştırabilir.”